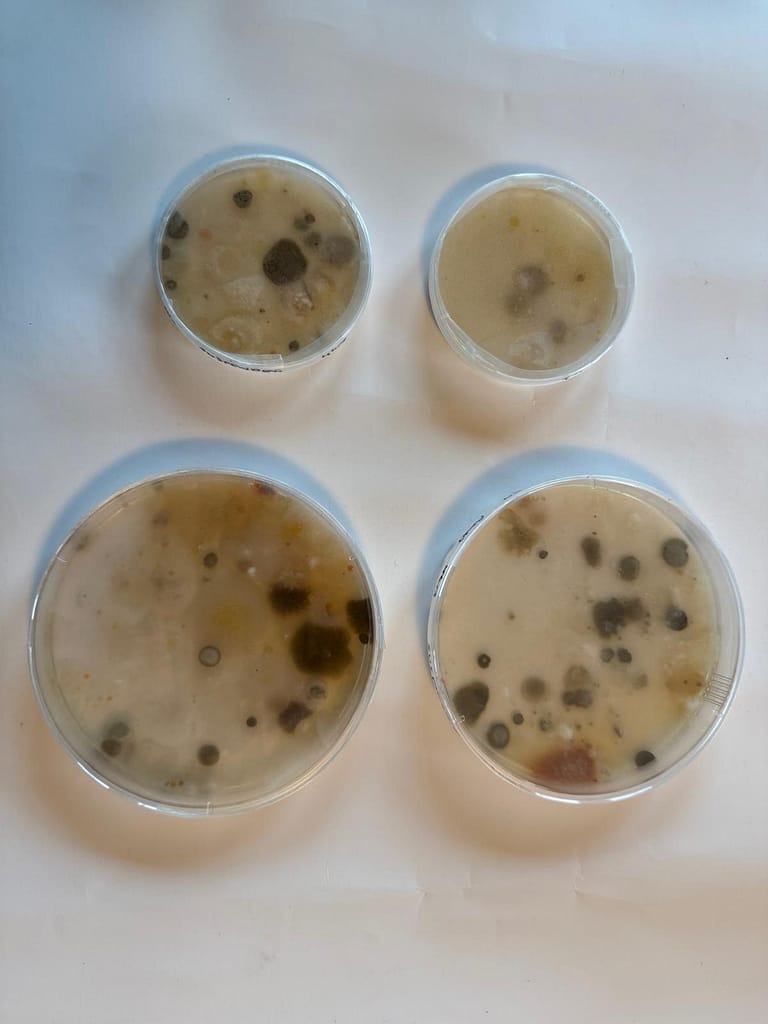

What happens if an Artist shadows a Forester for a year? What unexpected connections will be revealed? A 12-month artists residency is now underway that aims to explore artistic interpretations of the work of a forester, giving a chance to look at things in a new way.
The residency is a partnership between Andrew MacQueen, winner of the James Jones Trophy in the ‘New Commercial Woodland’ category at the 2023 Scotland’s Finest Woods awards, and Morag Paterson, Artist & Photographer. The residency is funded by an Eco Art award, with support also from Dumfries & Galloway Woodlands, with our grant from The National Lottery Heritage Fund.
Morag and Andy are working together through the year to consider new ways to interpret, highlight and understand the life in a forest.

With the residency already underway, Morag said:
I’m excited and grateful to be participating in The Curious Conversations – Into the Woods artists residency from now until 2025, with thanks to Eco Art and Dumfries and Galloway Woodlands for this opportunity.
I’ve already made several visits to Crofthead to speak with Andrew about all aspects of the forest—ranging from tree species selection and combinations, the impact of pathogens, the role of ‘nurse’ plants in tree establishment, to experimental thinning techniques, management strategies, folklore, and policy. His profound knowledge and genuine passion for the forest are both fascinating and inspiring, already sparking ideas for experimental happenings.
One area we hope to delve into is the forest’s air—exploring the microbes it contains, their interactions with the trees, and their effects on us. Next up, I’ll be heading up to Ascus Labs in Edinburgh to create devices for measuring airborne microbes. Once we have those findings, we’ll see where the conversation leads!

Andy added:
“Foresters often talk about silviculture as being equal parts science and art, requiring both head and heart, so it seems entirely appropriate to be blurring the boundaries between disciplines. It’s all too easy for any land manager to end up in orthodox silos which can over time erode curiosity in our work so the openness of the brief of the project has been hugely refreshing and I’m looking forward to seeing where it takes us.”
The results of the residency will be highlighted through a number of channels, including Dumfries & Galloway Social media accounts.
Dumfries & Galloway Woodlands works with a range of partners including Woodland Trust Scotland, Dumfries & Galloway Council and The National Lottery Heritage Fund. For more information about Dumfries & Galloway Woodlands, follow the facebook or twitter pages, visit the website www.dgwoodlands.org.uk or sign up for the newsletter here: http://eepurl.com/iAlL6k.
Dumfries & Galloway Woodlands is registered in Scotland as a SCIO, number 052525.
For any further info, please contact mcnabb.laurie@dgwoodlands.org.